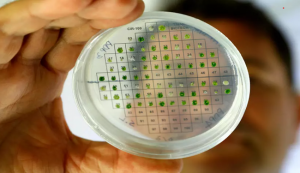

Bilim
Atomaltı Parçacık Skyrmionların Aynı Hücreler Gibi Bölündüğü Keşfedildi
ABD Enerji Bakanlığı Ames Laboratuvarı’ndan bir çeşit kuazi parçacık olan skyrmionların aynı canlı hücreler gibi bölünerek ürediğini keşfetti. Bu atomaltı

ABD Enerji Bakanlığı Ames Laboratuvarı’ndan bir çeşit kuazi parçacık olan skyrmionların aynı canlı hücreler gibi bölünerek ürediğini keşfetti. Bu atomaltı

Yeni Zelanda’nın Christchurch şehrinde, kuş lehçeleri üzerine çalışan ekolog Laura Molles, kuşların da tıpkı insanlar gibi farklı lehçeler konuştuğunu ve bir kuşun
“Bulgularımız sayesinde yapmayı düşünebileceğimiz birçok şey ortaya çıktı. Gelecek bize hangilerini yapabileceğimizi gösterecek” İsrailli bilim insanları bitkilerden hidrojen ürettiklerini söyledi.